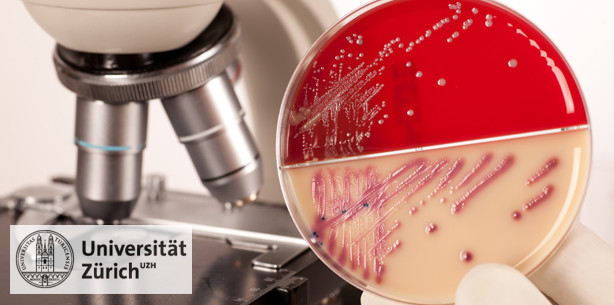
Bakterienkiller, der die Ohren verschont

Branchenmeldungen 13.06.2012
Bakterienkiller, der die Ohren verschont
Die Behandlung schwerer bakterieller Infektionen durch Aminoglykosid-Antibiotika kann mit gravierenden Nebenwirkungen wie irreversiblen Hörschäden und Taubheit einhergehen. Medizinischen Mikrobiologen der Universität Zürich ist es gelungen, die bakterizide Wirkung eines Aminoglykosids von seinem Gehör schädigenden Nebeneffekt zu trennen. Nun können Aminoglykoside entwickelt werden, die effektiv, aber weniger toxisch sind.
Aminoglykosid-Antibiotika bekämpfen Krankheitskeime im menschlichen Körper und helfen dort Infektionen einzudämmen. Weil diese Wirkstoffe gegen ein breites Spektrum von Bakterien wirksam sind und wenig kosten, gehören Aminoglykoside zu den weltweit am häufigsten verwendeten Antibiotika. Sie werden vor allem bei der Behandlung von schweren bakteriellen Infektionen verwendet und bei der gefürchteten Form der multiresistenten Tuberkulose. Aminoglykosid-Antibiotika hemmen die Protein-Synthese in den Krankheitserregern. Die Antibiotika dringen in die Bakterien ein und binden dort an die Protein-Bildungsstätten der Zelle, die Ribosomen. Blockiert durch die Aminoglykoside stellen die Ribosomen ihre Arbeit ein – die Bakterien sterben ab.
Taub wegen Antibiotika-Behandlung
Auch die menschliche Zelle verfügt über Ribosomen als Ort der Proteinherstellung. Dem Bakterien-Ribosom besonders ähnlich ist das Ribosom des menschlichen Mitochondriums, das Energie liefernde Kraftwerk der Zelle. Als unerwünschter Seiteneffekt vermag das Antibiotikum an mitochondriale Ribosomen zu binden, was mit schwerwiegenden Nebenwirkungen einhergeht. Die schwerwiegendste Begleiterscheinung von Aminoglykosiden sind irreversible Hörschäden und Taubheit.
Bakterien abtöten, ohne Hörverlust zu verursachen
Nun hat Prof. Erik Böttger, Mikrobiologe an der Universität Zürich, in Zusammenarbeit mit Forscherkollegen aus England, den USA und der ETH Zürich herausgefunden, dass das strukturell einzigartige Aminoglykosid Apramycin gegen eine grosse Bandbreite an Bakterien wirkt, aber keinen Hörverlust verursacht. «Es ist uns gelungen, bei Apramycin die bakterizide Wirkung eines Aminoglykosids von seinem Gehör schädigenden Nebeneffekt zu trennen», erklärt Böttger. Bis anhin ist Apramycin ausschliesslich in der Tiermedizin verwendet worden. Mithilfe zahlreicher Experimente zu Struktur, Biochemie und Toxizität können die Forscher zeigen, dass sich Apramycin zur Behandlung von Infektionskrankheiten des Menschen ebenso gut eignet, wie übliche in der Humanmedizin verwendete Aminoglykoside, ohne jedoch deren toxischen Charakter zu teilen und Hörschäden zu verursachen.
Bereits im Jahre 2008 gelang es Böttger und seiner Forschungsgruppe den Zusammenhang zwischen Aminoglykosiden, Mitochondrien und Hörverlust auf mechanistischer Ebene zu klären. Die Wissenschaftler bedienten sich dazu eines einzigartigen genetischen Modells, mittels dessen sie die menschliche Gensequenz, an der die Aminoglykoside andocken, in ein Bakterium einschleusten. Darauf aufbauend starteten Böttger und sein Team zusammen mit Prof. Andrea Vasella von der ETH Zürich ein chemisches Syntheseprogramm mit dem Ziel, ein Aminoglykosid-Antibiotikum zu entwickeln, das die Nebenwirkung der Taubheit nicht mehr aufweist. Im Rahmen dieser Arbeiten stiessen die Forscher auf Apramycin.
Aminoglykoside ohne Nebenwirkungen
«Der Weg zur Weiterentwicklung der wichtigen Antibiotika-Klasse der Aminoglykoside scheint nach jahrzehntelanger Forschung eine Alternative gefunden zu haben», so Böttger. Mit dem neuen Wissen steht einer Veränderung von Aminoglykosiden, die effektiv, aber weniger toxisch sind, nichts mehr im Wege.
Literatur:
Tanja Matta, Chyan Leong Ng, Kathrin Lang, Su-Hua Sha, Rashid Akbergenov, Dmitri Shcherbakov, Martin Meyer, Stefan Duscha, Jing Xie, Srinivas R. Dubbaka, Déborah Perez-Fernandez, Andrea Vasella, V. Ramakrishnan, Jochen Schacht, and Erik C. Böttger. Dissociation of antibacterial activity and aminoglycoside ototoxicity in the 4-monosubstituted 2-deoxystreptamine apramycin. PNAS. 11 June, 2012. Doi: 10.1073/pnas.1204073109
Quelle: Uni Zürich